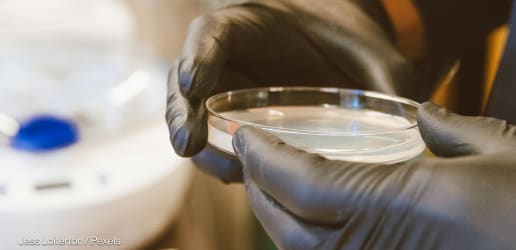
Kenya limits US access to disease outbreak data in new bilateral deal

1 day ago // The Future of Global Health
U.S. lawmakers released a foreign assistance appropriations bill that allocates $9.4 billion for global health.

3 days ago // The Future of Global Health
Six months ago the Trump administration said it would cut funding for Gavi but the U.S. Senate and House of Representatives included funding for it in its foreign assistance appropriations bill.

4 days ago // The Future of Global Health
Staff cuts, loss of expertise, shuttered programs, and the withdrawal from the World Health Organization are worrying those who’ve invested deeply in the agency's decades-long work in global health.

25 days ago // The Future of Global Health
Negotiations with Zambia and Nigeria are the most stark examples of where the Trump administration has made explicit terms around nonhealth metrics it wants in return for aid.

30 days ago // Devex Pro Live
“Organizations will remain relevant to the extent that they shift and understand the countries are in charge, which is what should have happened a long time ago,” says Dr. Mark Dybul.

about 1 month ago // The Future of Global Health
Many are concerned that the State Department is signing these agreements with countries too fast and without public participation.
about 1 month ago // The future of global health
“We did not negotiate a specimen-sharing agreement,” said Kenyan Ministry of Health's Dr. Ouma Oluga. “This is something that they really wanted but we said: ‘Wait a minute, we will not do it.’”

about 1 month ago // The Future of Global Health
U.S. Secretary of State Marco Rubio called the East African nation a "perfect partner" to serve as a proof-of-concept in efforts to create "a sustainable U.S. health assistance model." Kenya's Ministry of Health called it "quite a departure from the past."

about 1 month ago // The future of global health
In the wake of mass foreign aid cuts, the global health sector can learn lessons from The END Fund’s private sector, collaborative approach.

about 2 months ago // The Future of Global health
African Christian faith leaders gathered in Nairobi this week. While the U.S. State Department said it will leverage faith-based organizations in its new approach to global health, there’s concern over whether African governments will funnel money to them.